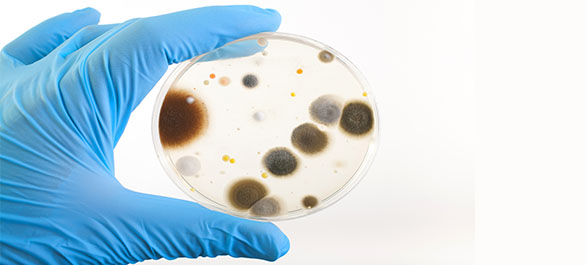
แบคทีเรียกินเนื้อ-3

on
แบคทีเรียกินเนื้อ (ตอนที่ 3 และตอนจบ)
2 กันยายน 2017
อาการต่อมาที่เป็น ได้แก่
- ผิวหนังเปลี่ยนไป เช่น เป็นแผลผุพอง (Skin ulceration) และ เป็นตุ่มน้ำใส (Bullae)
- สีผิวเปลี่ยนไป (Skin discoloration)
- แผลตายเฉพาะส่วน (Necrotic scars)
- มีแก็สในเนื้อเยื่อ
- แผลมีน้ำหนอง
- ช็อกเหตุพิษติดเชื้อ (Septic shock) โดยมีการติดเชื้อในกระแสเลือด (Bacteremia) ความดันต่ำ หายใจเร็ว ระดับความรู้สึกตัวเปลี่ยนไป (Altered mental status)
- อวัยวะล้มเหลว
- เสียชีวิต
แพทย์สามารถวินิจฉัยโรคได้ด้วยการพิจารณาว่า อาการเกิดขึ้นเมื่อไรและมีการติดเชื้อกระจายเร็วขนาดไหน นอกจากนี้อาจมีการนำเนื้อเยื่อไปทดสอบเชื้อแบคทีเรีย และตรวจว่ามีการกระจายของเชื้อไปมากขนาดไหนด้วยการเอ็กซเรย์ ซีทีสแกน หรือ เอ็มอาร์ไอ
การรักษาที่รวดเร็วเป็นสิ่งสำคัญของโรคนี้ ยิ่งเร็วเท่าไร ยิ่งมีโอกาสที่จะหายและไม่มีอาการแทรกซ้อนที่รุนแรง เช่น การตัดแขนขา (Limb amputation) หรือการเสียชีวิต
ทั้งนี้ การรักษาอาจทำได้ด้วยการ
- ผ่าตัดเอาเนื้อเยื่อส่วนที่ติดเชื้อออกเพื่อหยุดการแพร่กระจายของเชื้อ ซึ่งบางคนอาจต้องผ่าตัดหลายครั้งเพื่อควบคุมการติดเชื้อให้ได้
- ใช้ยาปฏิชีวนะเพื่อฆ่าเชื้อแบคทีเรียเบื้องต้น เช่น ยา Penicillin ยา Clindamycin ยา Metronidazole ยา Cephalosporins ยา Carbapenems ยา Vancomycin และยา Linezolid ภายหลังจากเพาะเชื้อแล้วทราบชนิดของเชื้อ จึงให้ยาฆ่าเชื้อเฉพาะ
- รักษาอาการแทรกซ้อนที่เกิดขึ้น เช่น ช็อก หายใจไม่ได้ หรือ อวัยวะล้มเหลว
- การรักษาผู้ป่วยด้วยออกซิเจนความดันบรรยากาศสูง (Hyperbaric oxygen therapy) ซึ่งสามารถลดอัตราการเสียชีวิตลงได้ร้อยละ 10-20
การรักษาที่เร็วจะทำให้ผู้ป่วยมีโอกาสรอดชีวิตและมีรอยแผลเพียงเล็กน้อย แต่ถ้าเป็นแผลใหญ่อาจใช้การปลูกถ่ายผิวหนัง (Skin grafting) และหากจำเป็นอาจต้องทำการตัดแขนขาหรืออวัยวะเพื่อรักษาชีวิตไว้ ทั้งนี้ขึ้นกับความรุนแรงของเชื้อและบริเวณที่ติดเชื้อ
สำหรับการป้องกันโรคนี้ ทำได้โดย
- ล้างมือให้สะอาดด้วยน้ำและสบู่บ่อยๆ
- หากเป็นแผล ให้รีบรักษาทันที ทำแผลให้แห้งสะอาด
- ปกปิดบาดแผลให้เรียบร้อย
- ใช้เครื่องมืออุปกรณ์ที่สะอาด เช่น อุปกรณ์ทำแผล อุปกรณ์ในห้องผ่าตัด เป็นต้น
แหล่งข้อมูล:
- Necrotizing fasciitis. [2017, August 31].
- Necrotizing Fasciitis (Flesh-Eating Bacteria) - Topic Overview. [2017, August 31].
- 1. Necrotizing Fasciitis (Flesh-Eating Disease). [2017, August 31].